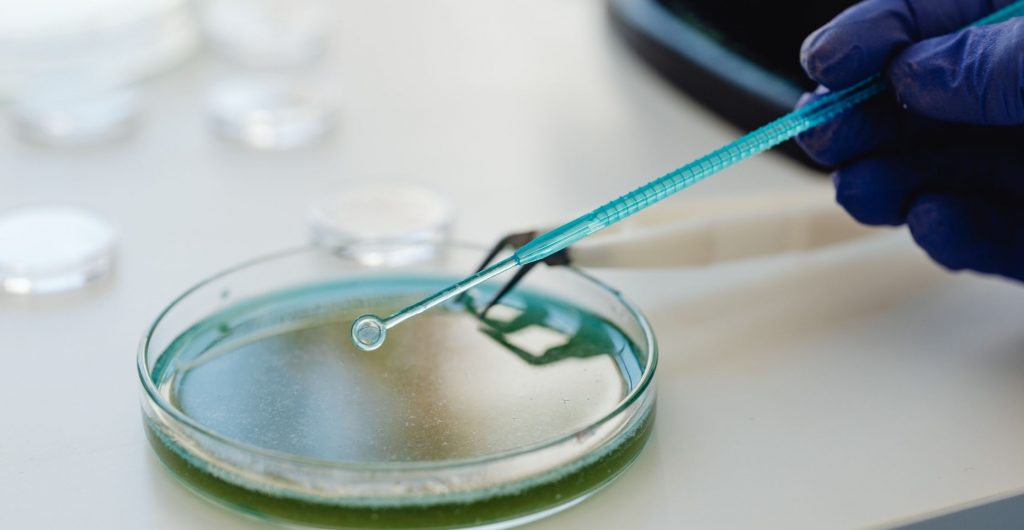
Top Non-Ionic Surfactants for Textile Processing

Ethoxylated Surfactants Explained: Ethoxylates, Alkoxylates & Their Uses
Specialty Chemicals B2B for South / Latin America with SBR International, Germany’s expert in chemical products of Emulsifiers, Surfactants, Agrochemicals, Pesticides, Fertilizers and more.